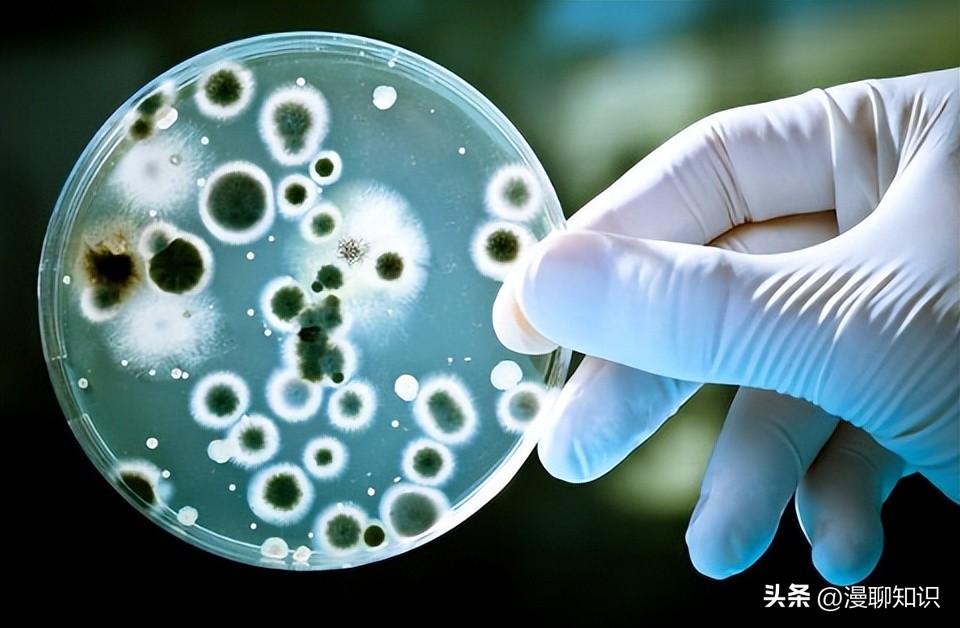
慢性复发性骨髓炎儿童案例,青少年得慢性骨髓炎能治好吗

阅读文章前,辛苦您点下右上角的“关注”,方便您讨论分享,持续关注每日优质内容~
对不能解释为感染或恶性肿瘤等继发的复发性或持续性炎症性病变,应考虑自身炎症性疾病,在大多数病例中,该类疾病临床表现首先出现在儿童时期。
由于自身炎症性疾病的发生率低、临床表现非特异性且多样、无特异性生物标志物、基因识别不明确,该类疾病诊断常被延迟。
慢性非细菌性骨髓炎(chronic nonbacterial osteomyelitis, CNO)是自身炎症性疾病中基因突变不明的一种病变,曾称Garré骨髓炎、弥漫性硬化性骨髓炎、原发性慢性骨髓炎、儿童下颌慢性骨髓炎等,慢性复发性多灶性骨髓炎(chronic recurrent multifocal osteomyelitis, CRMO)是较为严重的类型。
CNO可作为综合征的一部分或单独表现,通常影响儿童和青少年,具有骨骼肿痛反复发作的特征,单病灶的发病率在10%~56%,且单病灶多发生在下颌骨。
本文将主要从CNO的发病机制、诊断标准和治疗原则等方面进行综述。

关于CNO的发病机制目前尚不清楚,主要有基因突变学说、慢性感染病原体学说、先天免疫系统过度激活学说、促炎因子与抗炎因子失衡学说4种观点。
CNO疾病的易感基因可能位于18号染色体的q21.3~q22部位。
在南亚无血缘关系的CNO患者中检测到细丝蛋白结合LIM蛋白1(filamin-binding LIM protein 1,FBLIM1)基因细丝蛋白结合域的一个纯合突变和一个复合杂合突变。
FBLIM1是一种抗炎分子,通过细胞外信号调节激酶1/2(extracellular-signal regulated kinase 1/2,ERK1/2)磷酸化激活核因子κB受体活化因子配体(receptor activator of nuclear factor-κB ligand, RANKL)来调节骨重塑。

有研究在小鼠ENU(点诱变剂n-乙基-n-亚硝基脲)诱变筛选中分离出存在关节和骨骼自发炎症的Ali18小鼠,通过测序发现Src家族激酶(SFK)成员FGR C端调控区有一个错义突变,且该小鼠炎症依赖于FGR产物。
通过全外显子组测序和基因表达微阵列可发现可能的CRMO易感基因。
对99例CRMO患者进行全外显子组测序,发现13例患者的FGR中存在杂合子编码序列变异,包括2个影响激酶活性的错义突变蛋白。

脯氨酸-丝氨酸-苏氨酸相互作用蛋白2(proline-serine-threonine phosphatase-interacting protein 2,PSTPIP2),也被称为巨噬细胞激动相关蛋白和酪氨酸磷酸化蛋白(macrophage active-associated protein and tyrosine phosphorylation protein, MAYP),基因定位于小鼠和人类的18号染色体上。
PSTPIP2能够抑制炎症和破骨细胞生成,当基因缺陷时会引起集落刺激因子(colony stimulating factor 1,CSF-1)信号传导增强,CSF-1能诱导巨噬细胞及其前体细胞增殖,ERK1/2为其主要调节因子。
PSTPIP2突变尚未在CNO患者中证实,但小鼠PSTPIP2基因的L98P突变可导致严重的自身炎症性骨疾病,类似于人类的CRMO,这些小鼠被称为PSTPIP2cmo小鼠。

动物实验表明中性粒细胞在PSTPIP2cmo小鼠的自身炎症性骨疾病诱导中不可或缺,胞内独特的NLRP3/caspase 1和caspase 8两种复合物的激活引发过量的IL-1β产生,当两种caspase在PSTPIP2cmo小鼠中均缺乏时可显著预防骨疾病。
一些相关的自身炎症性综合征目前已发现有明确的单基因突变,如Majeed综合征中LPIN2隐形突变,白介素(interleukin, IL)-1受体拮抗剂缺乏症(deficiency of interleukin-1 receptor antagonist, DIRA)中IL1RN隐形突变,化脓性关节炎-坏疽性脓皮病-*疮痤**综合征(pyogenic arthritis, pyoderma gangrenosum, acne syndrome, PAPA)中PSTPIP1基因突变。

目前未从CNO患者的血液或感染灶区中分离出病原菌,且抗菌类药物不能改善症状。
也有学者认为可能存在潜在的未被人类识别的微生物,或微生物群的紊乱改变了免疫细胞的分布,从而引发一些疾病的炎症表现。
内源性分子在无菌条件下可触发异常的先天性和适应性免疫反应。
在自身炎症性疾病中,NLR信号通路突变可导致炎性小体结构性激活,从而引起先天免疫系统的过度激活;caspase 1通过切割IL-1β前体和IL-18前体激活IL-1β和IL-18。

随着研究的深入,目前CNO发病机制逐渐倾向于促炎因子与抗炎因子失衡学说。
当肿瘤坏死因子α(tumor necrosis factor-α,TNF-α)、IL-1β、IL-6、IL-20等促炎因子表达水平升高,IL-10、IL-19等抗炎因子表达水平减少时可引起全身及骨的炎症。
TNF-α、IL-1、IL-6可能通过增强核因子κ B受体活化因子(receptor activator of nuclear factor-κ B,RANK)及其可溶性配体RANKL作用于破骨细胞前体细胞,导致破骨细胞分化和活化增加。
IL-10表达减少可由多种因素引起,包括转录因子网络的中断、基因组变异和表观遗传模式改变。

有研究发现,在CNO患者中,丝裂原活化蛋白激酶(mitogen-activated protein kinase, MAPK)、ERK1/2激活减少可引起IL-10表达受损,导致转录因子SP1(specificity protein 1)激活和核穿梭受损,并改变SP1到IL-10启动子的募集(转录起始位点上游-636/-627 bp)。
此外,ERK激活减弱也导致IL-10启动子组蛋白H3S10磷酸化减少
另有研究发现,脂多糖激活toll样受体4(toll-like receptor 4,TLR4)后,CNO患者的单核细胞无法表达免疫调节因子IL-10。
单核细胞中表观遗传重塑改变(H3S10磷酸化、DNA甲基化)和SP1激活受损,引起CNO患者单核细胞中IL-19表达减少。

CNO患者的单核细胞中IL-20 DNA甲基化减少,也可能引起促炎因子IL-20表达增强。
由其他MAPK亚家族包括JNK/p38 MAPK诱导的促炎因子(TNF-α、IL-6)表达增加,导致促炎/抗炎值增加,并向促炎信号失衡。
目前国际上尚无CNO的诊断标准,故其诊断仍属于排除性诊断,需与朗格汉斯组织细胞增生症、感染性骨髓炎、骨纤维异常增殖症和Paget骨病等其他疾病加以鉴别。
以下4个方面可能提示CNO的存在。
CNO的临床表现主要为:①具有复发性、间歇性等特点,多灶性较多。
②病灶部位骨骼疼痛和局限性压痛,局部也可能出现红肿,无脓肿、瘘管或死骨形成。
③无感染源病灶。
④骨外器官还会出现皮肤银屑病、掌跖脓疱病、*疮痤**、肠道炎症、滑膜炎等。
⑤50%儿童患者的一级或二级家属患有银屑病、克罗恩病、溃疡性结肠炎等。
⑥大部分患者使用非甾体抗炎药(non-steroidal anti-inflammatory drugs, NSAIDs)后能改善病情。

儿童的平均发病年龄9~10岁,约70%患者为女性,好发于下肢骨(超过50%)、脊椎(3%~30%),锁骨(10%~30%)、骨盆(16%)、前胸壁(11%~13%)、下颌骨(2%~5%)等。
累及脊椎的CNO可能会导致患者脊椎压缩性骨折和脊椎塌陷,出现脊柱后凸、侧凸、压迫性损伤等;累及生长板的CNO可能导致患者骨骺提前闭合,进而发展成肢体畸形;累及下颌骨患者将出现张口受限、髁突动度消失,严重的出现骨性强直。

实验室检查目前没有特异性生物标志物,多是炎症标志物,如白细胞计数正常,血沉、C反应蛋白等轻度升高或正常。
促炎细胞因子如TNF-α和IL-6增加,而抗炎细胞因子减少,特别是IL-10。
7%~33%的患者会有总免疫球蛋白IgG及其亚类IgG1、IgG2、IgG3以及IgD的升高。
细菌培养多为阴性。

影像学检查呈亚急性或慢性骨髓炎表现,初期X线表现可能正常,之后逐步呈溶骨性和(或)成骨性改变,后期可表现为受累骨骼骨破坏伴边缘硬化。
骨膜反应的程度取决于疾病的持续时间和所涉及的解剖部位。
MRI对疾病早期高度敏感,可在骨破坏和硬化形成之前检测到骨髓水肿,并可评估周围软组织炎症反应。
全身MRI是一种很好的检查方法,它能够识别临床无症状病变,不过由于价格贵、患儿配合度不足等原因较少使用,考虑合并其他器官有典型特征时可酌情使用。
骨扫描可显示骨关节多发的异常的放射性浓聚,早期放射性物质摄取提示炎症,晚期放射性物质摄取提示骨硬化,其缺陷是生长板的生理性高摄取且对儿童及青少年有一定辐射损伤。

骨组织活检可排除慢性感染、恶性肿瘤或其他疾病,CNO通常表现为非特异性骨髓炎,早期主要有中性粒细胞、巨噬细胞等炎性细胞浸润和骨质溶解;慢性期可见反应性骨生成、骨硬化、骨纤维化和骨增生,以淋巴细胞浸润为主,同一活检标本中可见急性、亚急性、慢性炎性反应并存。
当患者表现为单灶性病变难以诊断时可通过骨活检明确,若临床表现较为典型(如多灶性、反复性、存在其他器官表现等),可减少这类创伤性检查。

有学者认为CNO有自限性,治疗主要以缓解症状、促进骨愈合、避免畸形、预防复发为目标,通常以药物治疗为主。
目前较为认可的一线药物是NSAIDs, 但尚未发现哪种疗效最佳,NSAIDs在累及脊椎或有关节炎的CNO患者中疗效一般。
另有一项队列研究发现,虽然NSAIDs可以改善症状,但在疾病早期使用也不能阻止炎症的发展,长期有效率仅为11%。
糖皮质激素可在急性发作期迅速抑制炎症反应,常作为短期联合用药(最多6周),但因其使用剂量和间隔给药时间未达成共识,在青少年患者中应慎重考虑长期使用带来的不良反应。

双膦酸盐类药物在报道中的长期有效率达67%,适合对以成骨不全为主的CNO患者骨改建治疗,帕米膦酸盐显示在儿童中具有长期安全性和良好的耐受性。
由于剂量、给药间隔时间、不良反应等问题尚未解决,所以青少年的使用规范还需进一步研究,有研究报道停止帕米膦酸钠治疗8年后在患者尿液样本中仍检测到帕米膦酸盐。
另外帕米膦酸盐治疗还会引起不良药物反应,比如罕见但严重的肾功能不全。
接受双膦酸盐治疗的年轻患者发生药物相关性颌骨骨坏死的风险可能会降低。
抗风湿类药物被用于严重的、反复发作或多发的,且前两种药物无法控制的CNO患者,包括传统的非生物抗风湿类药物(如甲氨蝶呤或柳氮磺胺嘧啶)和TNF-α*制剂抑**、IL-1受体*制剂抑**等生物制剂。

非生物抗风湿类药物的疗效低于TNF*制剂抑**和双膦酸盐。
有研究显示,TNF*制剂抑**联合甲氨蝶呤使用,伴或不伴双膦酸盐的积极联合治疗都能缓解CNO患者临床症状,并显著降低影像学上的活动性病变。
也有研究显示英夫利昔单抗和依那西普可显著改善CNO患者炎症性疼痛、发热及炎性指标。
Anakinra是一种重组IL-1受体拮抗剂,也是首个获批的抗IL-1药物,被成功用于治疗各种单基因、多基因或不明原因的全身自炎性疾病。
有研究使用重组IL-1受体拮抗剂治疗儿童和成年CNO患者,显示其能够改善并控制病情。
对于难治性CNO(NSAIDs、糖皮质激素、帕米膦酸盐治疗无效)使用Anakinra治疗6个月后,56%患者的C反应蛋白和血沉恢复正常。

总的来说,临床缓解率较好的是帕米膦酸盐(67%)、TNF-α*制剂抑**(46%),其次是糖皮质激素(37%)、甲氨蝶呤(20%)、柳氮磺胺吡啶(18%)和NSAIDs(13%),柳氮磺胺吡啶和NSAIDs之间的临床反应差异无统计学意义,抗TNF治疗和帕米膦酸盐治疗的完全应答率显著高于NSAIDs单药治疗。
帕米膦酸钠在更年轻的患者中的治疗效果更好,并且比使用抗TNF治疗的患者起效更快。
其他具有前景的治疗方法仍处于动物实验或临床试验阶段,如RANKL阻滞剂和重组RANKL配体*制剂抑**可能减少破骨细胞活动和炎症性骨丢失,目前还没有关于这个治疗方案在患者中成功应用的报道。
还有研究表明PSTPIP2cmo小鼠被喂食富含脂肪和胆固醇的饮食后,保持了正常体重且对炎症性骨病和骨质侵蚀有明显的保护作用。

饮食诱导对骨髓炎的保护伴随着肠道普雷沃氏菌水平和中性粒细胞IL-1β前体表达的显著降低,提示在PSTPIP2cmo小鼠中,肠道普雷沃氏菌对小鼠炎症具有促进作用,而乳杆菌属具有保护作用。
许多研究也都强调了乳杆菌对宿主免疫系统的免疫调节作用,它和肠道相关免疫细胞之间相互作用诱导TLR2表达增加,是一种很有前途和潜力的治疗性益生菌。

CNO由于临床症状及辅助检查均无特异指标,诊断上易误诊或延迟诊断,目前仍以排除性诊断为主。
治疗药物有NSAIDs、糖皮质激素、双膦酸盐类、抗风湿药、TNF-α拮抗剂类等。
一般无严重的后遗症,当累及重要结构可能出现畸形。
在发病机制研究上目前更倾向抗炎因子和促炎因子的失衡,未来期望在基因和分子层面有更进一步的研究发现,并提供更好的治疗方法。